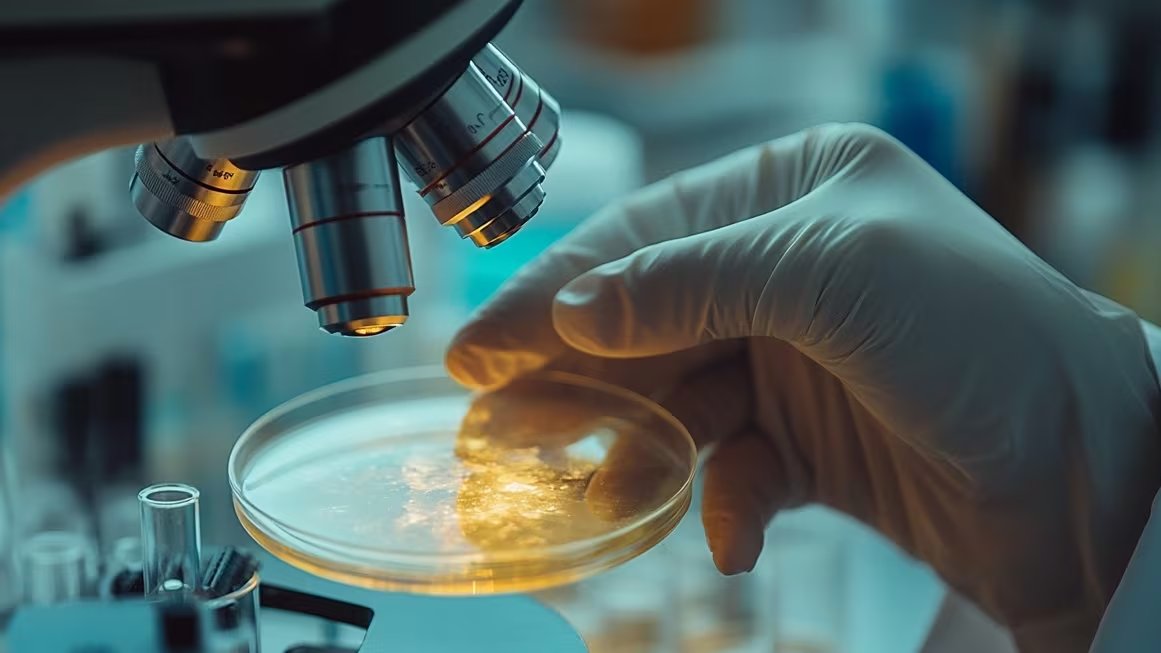
Novo Nordisk aseguró que el proceso regulatorio de la FDA no afecta la calidad ni el suministro de medicamentos destinados a la diabetes y control de peso (Imagen Ilustrativa Infobae)

La Administración de Alimentos y Medicamentos de Estados Unidos (FDA) ha emitido formalmente una carta de advertencia dirigida al gigante farmacéutico Novo Nordisk. El motivo de este llamado de atención es la omisión de datos fundamentales en el reporte de “efectos adversos graves e inesperados” detectados en pacientes que consumen sus terapias para el control de peso y el tratamiento de la diabetes.
El documento oficial, que fue publicado a principios de marzo, surge tras una rigurosa inspección llevada a cabo entre enero y febrero de 2025 en las dependencias del laboratorio ubicadas en Plainsboro, Nueva Jersey. En la misiva, el ente regulador demanda que la empresa —responsable de medicamentos de alta demanda como Ozempic y Wegovy (semaglutida)— detalle las acciones que tomará para subsanar los fallos en sus sistemas de vigilancia de seguridad y notificación.
Durante el proceso de auditoría, las autoridades sanitarias norteamericanas identificaron lo que describieron como “graves infracciones de los requisitos de notificación de PADE”. Este acrónimo se refiere específicamente a las experiencias adversas a medicamentos que ocurren una vez que los productos ya están en fase de comercialización masiva.
Es importante destacar que la FDA aclaró en su comunicación que la falta de notificación oportuna no implica, hasta este momento, que los medicamentos para la obesidad o la diabetes sean los causantes directos de los síntomas reportados. El cuestionamiento de la agencia no se centra en la seguridad intrínseca de la semaglutida, sino en la deficiencia de los protocolos internos de la farmacéutica para informar sobre cualquier incidente sospechoso.
De acuerdo con el informe de la inspección, Novo Nordisk falló en la creación y mantenimiento de procedimientos escritos que garanticen la correcta vigilancia, recepción y evaluación de las reacciones adversas. La FDA fue enfática al señalar en la carta:
“Esta carta de advertencia le informa sobre las condiciones objetables observadas durante la inspección de la FDA realizada en su empresa, Novo Nordisk Inc. entre el 13 de enero y el 7 de febrero de 2025”.

Entre las irregularidades detectadas por el organismo se encuentra la carencia de lineamientos claros de control, no solo dentro de la estructura corporativa de Novo Nordisk, sino también en las labores realizadas por contratistas externos. El portafolio bajo la supervisión de la empresa incluye principios activos como la semaglutida, liraglutida, nedosiran sódico y estradiol. La agencia subrayó que los protocolos vigentes “no garantizaron” el cumplimiento de las normativas de vigilancia post-comercialización exigidas por la ley.
Respecto a la clasificación de estos incidentes, la FDA define un evento adverso como: “Cualquier evento adverso asociado con el uso de un medicamento en humanos, ya sea que se considere relacionado con el medicamento o no”. Hasta la fecha, las medidas correctivas que el laboratorio ha intentado implementar han sido calificadas como insuficientes por el regulador.
En un fragmento clave de la notificación, la FDA expresa su descontento con la respuesta previa de la compañía:
“Su respuesta escrita y la correspondencia posterior son insuficientes porque no proporcionó suficientes detalles para que la Agencia determine si sus acciones resolvieron eficazmente los problemas existentes y evitarán infracciones similares en el futuro. En concreto, no proporcionó suficientes detalles sobre cómo sus procedimientos, directrices y materiales de capacitación actualizados garantizarán el cumplimiento futuro de la notificación oportuna de ADE graves e inesperados a la FDA”.
Esta carta no solo representa un llamado de atención, sino que impone un plazo perentorio de 15 días hábiles para que Novo Nordisk entregue un informe detallado con las medidas adoptadas para evitar que estas fallas se repitan. De no corregirse la situación, la farmacéutica podría enfrentarse a acciones regulatorias más severas por parte del gobierno estadounidense.

La FDA también advirtió que las observaciones mencionadas en el documento no son necesariamente una lista completa de todas las deficiencias que podría tener el laboratorio. En ese sentido, recordó que es responsabilidad constante de la empresa ajustarse a los marcos legales de Estados Unidos. El propósito final de estas exigencias es asegurar que se envíe información de seguridad precisa y confiable para el monitoreo continuo de los fármacos en el mercado.
Este procedimiento forma parte del Programa de Monitoreo de Bioinvestigación, un esquema que utiliza inspecciones periódicas para verificar que las normativas PADE se cumplan estrictamente tanto en la documentación como en los procesos operativos internos de las farmacéuticas.
La postura de Novo Nordisk ante las observaciones
Tras la difusión de la noticia, Novo Nordisk reconoció haber recibido la notificación oficial. La compañía danesa aclaró que el objetivo de la FDA es obtener información técnica adicional para validar el cumplimiento normativo y que la carta “no llega a ninguna conclusión sobre la calidad o seguridad de nuestros medicamentos”.
El laboratorio aseguró que ya ha puesto en marcha un plan de acción destinado a fortalecer sus protocolos de reporte y control post-comercialización. Asimismo, indicaron que han mantenido una comunicación fluida con la FDA, informando sobre sus avances tras la auditoría inicial de principios de año.
Según los registros de la empresa, tras recibir el informe técnico inicial (conocido como Formulario FDA 483), enviaron su primera respuesta el 3 de marzo de 2025. Desde aquel momento, han remitido un total de siete actualizaciones a la agencia detallando los ajustes realizados en su planta de Plainsboro.
No obstante, este no es el único frente abierto para la compañía. A finales de 2025, recibieron otra notificación de la FDA relacionada con las Buenas Prácticas de Manufacturación en su centro de producción de Bloomington, Indiana. Sobre este punto, la firma reiteró su compromiso de cooperar plenamente para optimizar cada uno de sus procesos industriales.
En términos de abastecimiento, Novo Nordisk comunicó que este proceso administrativo no afectará la producción ni la disponibilidad de sus fármacos. La dirección de la empresa sostiene que no prevén cambios en sus pronósticos financieros ni operativos para el presente año, manteniendo la confianza en que la situación se resolverá siguiendo los estándares del ente regulador.
Por su parte, portavoces del Departamento de Salud y Servicios Humanos (HHS) indicaron que la FDA se toma el tiempo necesario para evaluar minuciosamente cada evidencia antes de actuar, siempre con el fin de proteger la salud pública cuando se confirman infracciones a la normativa vigente.
Finalmente, la agencia recalcó en su comunicación oficial:
“Es su responsabilidad garantizar el cumplimiento de todos los requisitos legales y las regulaciones pertinentes de la FDA. Debe abordar cualquier deficiencia y establecer procedimientos para garantizar el cumplimiento de las regulaciones de la FDA”.
Esta acción regulatoria subraya la importancia de la transparencia en la industria farmacéutica, obligando a las empresas a reportar cualquier incidente sin filtrar eventos donde la relación causa-efecto aún no sea definitiva.
Fuente: Fuente

